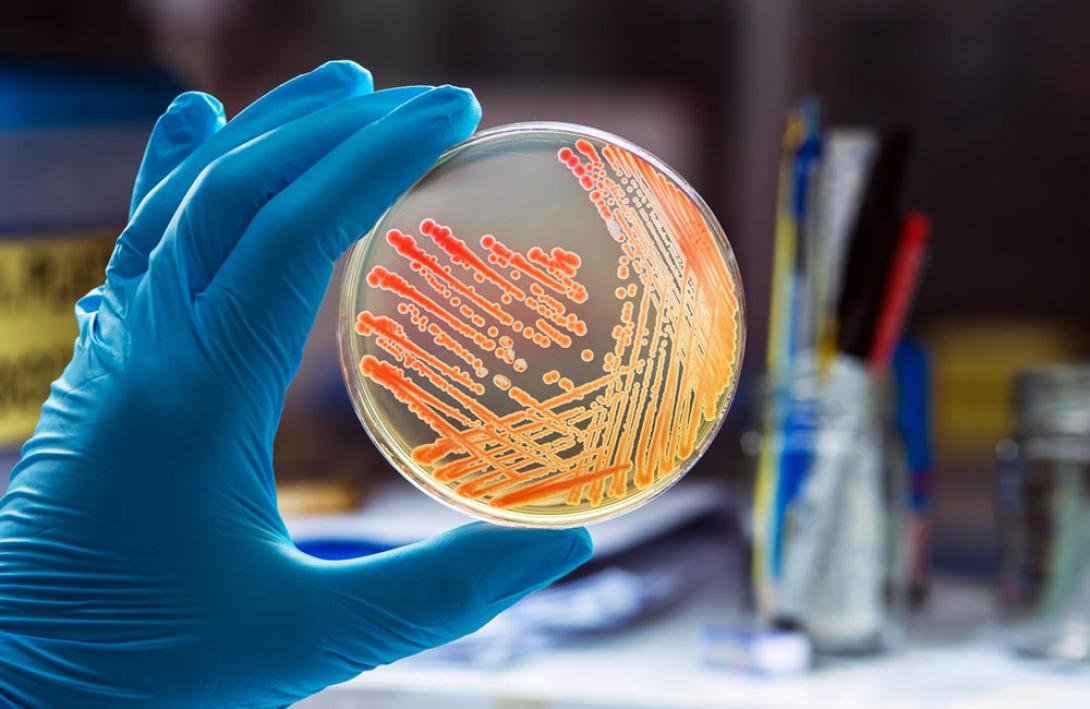
νοσος λεγεωναριων

Τις δράσεις του για την πρόληψη της «νόσου των λεγεωνάριων» στους ταξιδιώτες που επισκέπτονται την Ελλάδα, με στόχο τη διασφάλιση της Δημόσιας Υγείας , συνεχίζει ο ΕΟΔΥ.
Στο πλαίσιο της φετινής τουριστικής περιόδου έχουν προγραμματισθεί ενημερωτικές ημερίδες και στην Κρήτη, με θέμα: «Πρόληψη της Νόσου των Λεγεωναρίων σε ταξιδιώτες στην Ελλάδα».
Η λεγεωνέλλωση είναι οξεία βακτηριακή λοίμωξη του αναπνευστικού συστήματος , που σύμφωνα με τον Προϊστάμενο Διεύθυνσης Δημόσιας Υγείας Περιφέρειας Κρήτης Αντώνη Παπαδάκη, έχει θνησιμότητα που φθάνει στο 15% .
Πιθανές Πηγές μόλυνσης είναι:
§ Συστήματα παροχής κρύου – ζεστού νερού (ντους)
§ Πύργοι ψύξης συστημάτων κεντρικού κλιματισμού
§ Δεξαμενές αποθήκευσης νερού
§ Θερμές ιαματικές πηγές
§ Ιαματικά λουτρά
§ Πισίνες (ιδίως εκείνες όπου το νερό είναι ζεστό και διακινείται)
§ Σιντριβάνια
§ Υγραντήρες ατμόσφαιρας και αναπνευστικές συσκευές που λειτουργούν με νερό βρύσης
Μεταδίδεται αερογενώς με εισπνοή του βακτηριδίου, όταν νερό που είναι μολυσμένο διασκορπίζεται στον αέρα, υπό μορφή σταγονιδίων.
Δεν μεταδίδεται όμως, από άνθρωπο σε άνθρωπο.
Στις ομάδες υψηλού κινδύνου συμπεριλαμβάνονται όλα τα άνω των 50 ετών άτομα, οι καπνιστές, όσοι πάσχουν από χρόνιες πνευμονοπάθειες, σακχαρώδη διαβήτη, νεοπλασματικά νοσήματα και νεφρική ανεπάρκεια, όσοι έχουν υποβληθεί σε μεταμόσχευση οργάνων, άτομα με εξασθενημένο και ευάλωτο ανοσοποιητικό σύστημα.
Ο Προϊστάμενος Διεύθυνσης Δημόσιας Υγείας Περιφέρειας Κρήτης, τονίζει ότι οι ξενοδοχειακές μονάδες ,τα νοσοκομεία και όλοι οι χώροι που έχουν υδρόψυκτα συστήματα κλιματισμού πρέπει να κάνουν σωστή συντήρηση , ώστε να ελαχιστοποιείται ο κίνδυνος να νοσήσουν άνθρωποι από το επικίνδυνο αυτό βακτήριο.
ΔΙΑΒΑΣΤΕ ΕΠΙΣΗΣ:
Ηράκλειο - Βόμβα Ελεγκτικού: Ζητούν πίσω από τον Δήμο 12 εκατ. ευρώ για το Πολιτιστικό Κέντρο!
Σισαμάκης στο Ράδιο Κρήτη: Στις αρχές Ιουλίου παραδίδεται σε χρήση η Πλατεία Ελευθερίας